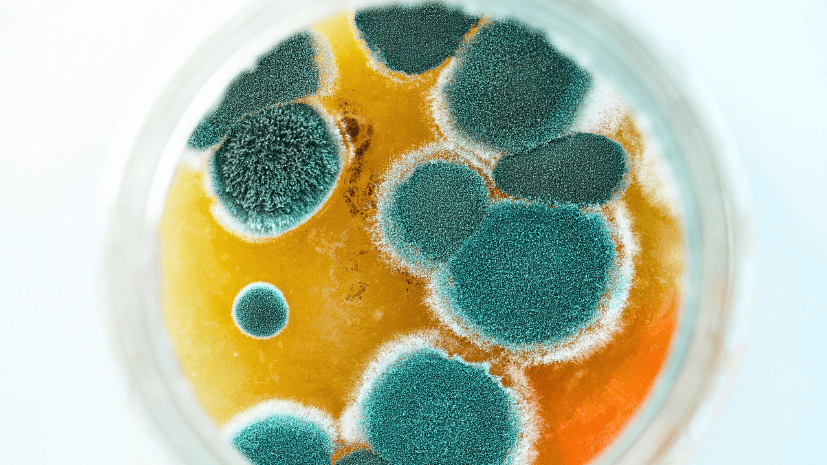
how air scrubbers work

You sometimes experience drastic events in a home, such as construction, renovation, and mold growth, which lead you to a full home restoration within the inside space. The mold is a big problem that can be found anywhere, no matter the condition and environment or if you’re experiencing chilliness or scorching seasons. It’s a fast-growing invader that infests your home and causes poor air quality, damaging home surfaces. It can also lead to health issues for the residents who come into contact with this indoor space.
Once you’ve figured out that you’re dealing with mold, remediation and mitigation are required. For this purpose, you need a mold air scrubber. Now, with the VEVOR air scrubber for mold remediation, you can prioritize your health and experience the power of the best brand to deliver excellent results.
Table of contents
Understanding Mold and Its Risks
Mold is from a fungus family that’s present both outdoors and indoors. It flourishes in dampness and humidity and spreads tiny spores in the air. These molds grow on spores or surfaces when the right conditions are met. Mold plays a vital role in breaking down dead organisms, but indoor growing mold can pose various risks.
Health effects are severe due to mold. Depending on the mold type, exposure and other factors lead to various diseases like asthma, respiratory system infections, skin irritation, sinus infection, fatigue, and headaches, weakening your immune system.
The Mechanics of Air Scrubbers
Air scrubbers for mold are a powerful tool that is built to improve indoor air quality by eliminating contaminants such as mold, dust, and other smaller particles.
In dry scrubbing, dry sorbents are used in the gas stream. However, wet scrubbing utilizes a liquid solution to remove pollutants from the air. Each method is remarkable and has its advantages. Based on the air pollutants and water availability, you can choose any of them to get the desired results.
VEVOR air scrubbers win the trust of many brands and allow you to live mold-free. From HEPA filtration to UV-C technology, this device utilizes cutting-edge technology to ensure the air is free from harmful bacteria.

The Role of HEPA Filters in Mold Remediation
HEPA filters are designed to capture the smallest particles, including microscopic particles such as pollens, bacteria, and viruses. HEPA enhances air quality by removing the smallest particles through mold air scrubbers. You can look at these steps to see the importance of HEPA filters for air scrubbers for mold.
1- Efficiency of Filtration
HEPA filters are remarkable for their high filtration efficiency. They’re built to trap the tiniest particles, as small as 0.3 microns, with a 99.97% accuracy. Due to this quality, they’re known for their effectiveness in trapping even the smallest particles in the air, especially those linked with mold.
2- Mold Removal
Mold air scrubbers are crucial in mold remediation and purifying the air. They can smoothly capture and remove mold from the air and prevent mold from spreading to other areas during cleaning.
3- Trapping Pathogens
Having a significant advantage in removing pathogens and allergens while maintaining clean and healthy air. People with allergies or respiratory diseases should buy air scrubbers for mold remediation.
4- Controlling Small Particles
Air scrubbers with HEPA filters help control particulate matter produced during cutting, sanding, or demolition in multiple construction and industrial places. Maintaining a healthy and safe environment plays a significant role.
5- Clean Up After Construction
Many times, air scrubbers stand among the many other purification devices during construction and renovation projects as debris, dust, and other smallest particles are produced during this process.
6- Used in cleanroom and hospital applications
HEPA filters in mold air scrubbers have the utmost importance for maintaining sterile conditions in places like hospitals and laboratories. It’s essential in removing contaminants and pathogens from the environment.
7- Enhance Air Quality
Removing large or small particles, HEPA filters improve indoor air quality. It’s beneficial for residents’ well-being benefit and health, especially in those places where people spend most of their time.
With a three-staged filtration process, such as a carbon filter, HEPA filter, and MERV, the VEVOR mold air scrubber efficiently cleans smoke, odors, and pollen while trapping 99.97% of particles. It results in quick indoor air quality improvements and allows you to enjoy a pleasant living environment.

Choosing the Right Air Scrubber for Your Home
Many mold air scrubbers tout fancy filtration systems to remove the air particles. But you need to look for an air scrubber with a built-in HEPA filter that can trap 99.97% of small particles with a 0.3-micron diameter. The rest is just frosting.
1- Size and Portability
To find the right air scrubber for mold remediation, you need to measure the room size where you need to install it. Ensure the portability, as you’ll need to move the mold air scrubber to different areas. So consider the unit’s weight, size, handles, and wheels’ accessibility to facilitate movement.
2- Power Consumption
Before buying the air scrubber for mold remediation, evaluate the level of noise where low noise is essential, such as offices, schools, and healthcare facilities. So, select a device with quiet operation to limit disruptions.
3- Filter Type
Determine what type of filters the mold air scrubber uses. Moreover, HEPA filters are the best and most effective in trapping the smallest particles, while carbon filters are essential to eliminate odors and gasses. Choose a unit that is suitable for your specific needs.
4- Budget
Cost is another crucial factor, as you can buy a VEVOR air scrubber for mold remediation for just $291, so invest wisely. But remember, there’s a maintenance cost and factors into your long-term spending plan. Depending on the brands and filters, you only need to replace the filter once after 6 or 12 months.
5- Warranty
Always check out the warranty offered by the manufacturer and customer support quality. If you face any problem, good customer support provides peace of mind.
FAQs about Air Scrubber for Mold
Can air scrubbers completely eliminate mold in my home?
Yes, it all depends on the mold air scrubber filters. As long as they’re highly efficient, they can remove mold and the smallest particles from the air.
Are air scrubbers effective against all types of mold?
Built with HEPA filters, the air scrubber for mold remediation can remove mold, dust, and bacteria.
How often should filters in air scrubbers be replaced for optimal mold remediation?
It’s recommended to replace the filter in between 6-12 months, taking the environment into account as consideration.
Is it safe to use air scrubbers in homes with children and pets?
Mold air scrubbers are built-in and used in homes around pets or children as their internal parts are safe for wagging tails.
Summing Up
Mold air scrubbers purify the air through continuous circulation, creating a healthier indoor environment. Air scrubbers for mold remediation are highly efficient during mold remediation while maintaining clean and safe air quality. In the fight against mold contaminations, mold air scrubbers create negative air pressure while employing powerful filtration.For cleaning air, buy mold remediation air scrubbers—choose VEVOR air scrubbers, such cutting-edge technology for your home and office. As you’re not just investing, you pay for your and your loved ones’ well-being.





